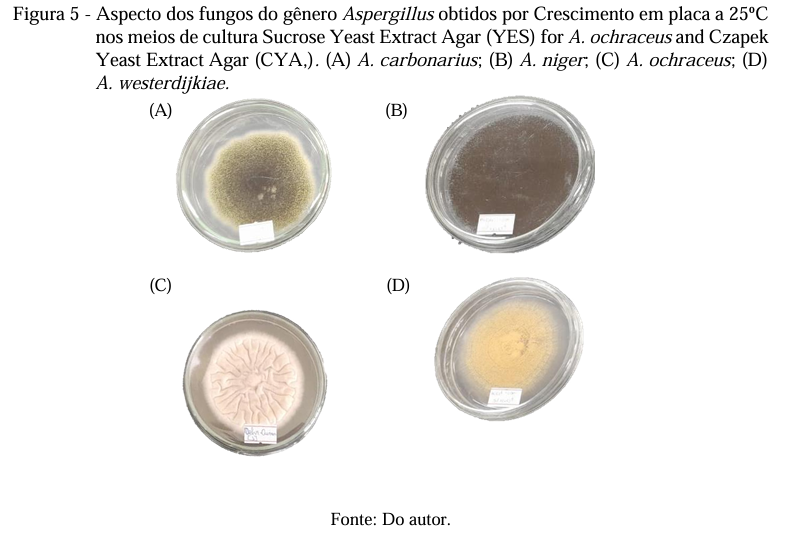

Por Simone Paiva – Analista de Comunicação da FUNDECC – 30 de Março de 2026.
Estudos conduzidos na universidade já apresentam resultados na inibição de micro-organismos e pragas, como alternativa para o uso de produtos sintéticos e ampliar soluções naturais na cadeia produtiva de alimentos
Para muita gente, os óleos essenciais ainda estão associados apenas ao aroma (presentes em difusores, cosméticos ou produtos de bem-estar). No laboratório, porém, eles revelam um potencial muito mais amplo.
Na Universidade Federal de Lavras (UFLA), pesquisas conduzidas no Laboratório de Química Orgânica – Óleos Essenciais investigam essas substâncias naturais como alternativas no controle de micro-organismos, na conservação de alimentos, na agricultura e até em aplicações voltadas à saúde.

“Os óleos essenciais vêm sendo largamente utilizados, principalmente pelas suas atividades biológicas, como fungicida, bactericida, inseticida e antioxidante”, explica a coordenadora das pesquisas, Maria das Graças Cardoso, Professora Titular do DQI e Pesquisadora 1A do CNPQ.
Extraídos de diferentes partes das plantas como folhas, flores, cascas, raízes e sementes, esses compostos orgânicos são sintetizados em pequenas quantidades, exercendo funções importantes para a própria planta.
“Eles são metabólitos secundários, formados em quantidade muito pequena, mas com papel importante na proteção e na adaptação da planta ao ambiente.”
Da extração ao entendimento químico
No laboratório, tudo começa com a extração pelo método de hidrodestilação, técnica que utiliza apenas água para extrair os compostos voláteis presentes no material vegetal.



A partir daí, os óleos passam por caracterização química e seguem para diferentes testes biológicos, realizados em parceria com outros departamentos da UFLA e de outras Universidades no país e no exterior.
“Um único óleo essencial pode ter até 50 compostos orgânicos”, explica a doutoranda Carolina Salles Freire.
Segundo ela, fatores como clima, solo, época do ano e parte da planta influenciam diretamente tanto o rendimento quanto a composição do óleo.
“A região de coleta, a temperatura e a umidade interferem muito. Isso impacta tanto a quantidade obtida quanto as propriedades do óleo.”
Resultados que avançam para a saúde
No doutorado, Carolina investiga diferentes aplicações dos óleos essenciais com foco na saúde humana.
O trabalho envolve testes de atividade antioxidante, antibacteriana, cicatrizante e antitumoral.
“Esse projeto envolve o estudo de bactérias que podem causar infecções de pele, como Staphylococcus aureus, além de estudos em células humanas para avaliar o potencial antioxidante, cicatrizante e antitumoral dos óleos essenciais.”
Aplicações no controle de pragas e parasitas
A mestranda Joyce Amélia Carvalho Silva trabalha com o óleo essencial de cominho, avaliando sua ação sobre bactérias, fungos e insetos associados a alimentos, especialmente o milho.

“Conseguimos resultados interessantes tanto com os fungos quanto com insetos. São organismos que afetam diretamente a qualidade dos alimentos.”
Entre os alvos estão os fungos dos gêneros Penicillium e Fusarium, além de insetos considerados pragas agrícolas.
Já a mestranda Juliana de Xisto Silva direciona os estudos para o controle de pragas e doenças que afetam a produção agrícola.
“Nosso objetivo é gerar dados que possam contribuir, futuramente, para o desenvolvimento de produtos voltados ao controle de insetos e fungos.”
Ela também trabalha com nanoemulsões, estratégia que permite aumentar a eficiência dos óleos e controlar a liberação dos compostos ativos.
A Dra. Danubia Aparecida de Carvalho Selvati Rezende realizou pesquisas com diferentes óleos essenciais com o objetivo de avaliar o efeito carrapaticida. Tais estudos se mostraram promissores, em baixas concentrações, para o controle desse parasita bovino (Rhipicephalus sanguineus).
Integração com tecnologias e resultados em alimentos
A Dra. Gabriela Aguiar Campolina avançou na aplicação dos óleos essenciais em sistemas voltados à conservação de alimentos, especialmente no controle de fungos e insetos.

“O que mais nos chamou a atenção ao longo da pesquisa foi perceber que os óleos essenciais não atuam apenas de forma isolada, mas podem ser integrados a tecnologias já existentes, como os revestimentos comestíveis, potencializando seus efeitos.”
Segundo ela, os resultados já indicam eficácia prática, principalmente em alimentos mais sensíveis.
“Obtivemos resultados expressivos na inibição de fungos e na redução da infestação por insetos, especialmente em frutas mais sensíveis, como o morango.”
Caminhos para aplicação na indústria
Outra pesquisa, foi a da Dra. Cássia Duarte Oliveira mostrando que os óleos essenciais atuam na interface entre os resultados laboratoriais e sua aplicação na área de alimentos, especialmente na conservação e segurança de produtos perecíveis.



No projeto, ela trabalhou com o uso de óleos essenciais associados a tecnologias como revestimentos comestíveis, com foco na redução de contaminações e no aumento da vida de prateleira.
“Isso mostra que é possível avançar para soluções mais naturais e eficazes, reduzindo a dependência de produtos sintéticos e contribuindo para uma cadeia produtiva mais segura e sustentável.”
Segundo a pesquisadora, um dos principais desafios está em transformar esses resultados em soluções viáveis para a indústria, considerando fatores como estabilidade dos compostos, liberação controlada e impacto sensorial nos alimentos.
A Dra. Danubia Aparecida de Carvalho Selvati Rezende realizou pesquisas com diferentes óleos essenciais com o objetivo de avaliar o efeito carrapaticida. Tais estudos se mostraram promissores, em baixas concentrações, para o controle desse parasita bovino (Rhipicephalus sanguineus).
Desafios e próximos passos
Apesar dos avanços, a pesquisa ainda enfrenta desafios importantes, entre eles, a variabilidade natural dos óleos essenciais.
“A maior dificuldade de trabalhar com óleo essencial é a variabilidade da composição”, explica a professora Graça.
Outro ponto está na sensibilidade desses compostos, que podem se degradar na presença de luz, calor e umidade.
Por isso, estratégias como nanoencapsulação e formulações controladas vêm ganhando espaço dentro da pesquisa.
Mais do que aroma
Embora muitos estudos ainda estejam em fase laboratorial, os resultados já acumulados mostram que a pesquisa com óleos essenciais na UFLA avançou para além da etapa inicial.
“A planta produz esses compostos para se proteger; e a gente quer estudar isso para também se proteger”, resume a professora.
Ciência que gera conhecimento e formação
Os estudos integram um projeto mais amplo que reúne diferentes áreas da UFLA e já apresenta resultados consistentes.

Ao todo, a linha de pesquisa contribuiu para o desenvolvimento de várias teses de doutorado, dissertações de mestrado e a formação de estudantes de iniciação científica, além da publicação de mais de 350 artigos científicos em periódicos nacionais e internacionais.
Os projetos contam com financiamento da FAPEMIG (Fundação de Amparo à Pesquisa do Estado de Minas Gerais) e do CNPq (Conselho Nacional de Desenvolvimento Científico e Tecnológico), com gestão administrativa e financeira da FUNDECC (Fundação de Desenvolvimento Científico e Cultural).
É essa estrutura que permite que a pesquisa avance, forme novos pesquisadores e amplie o uso de soluções naturais em diferentes áreas.






Deixe um comentário